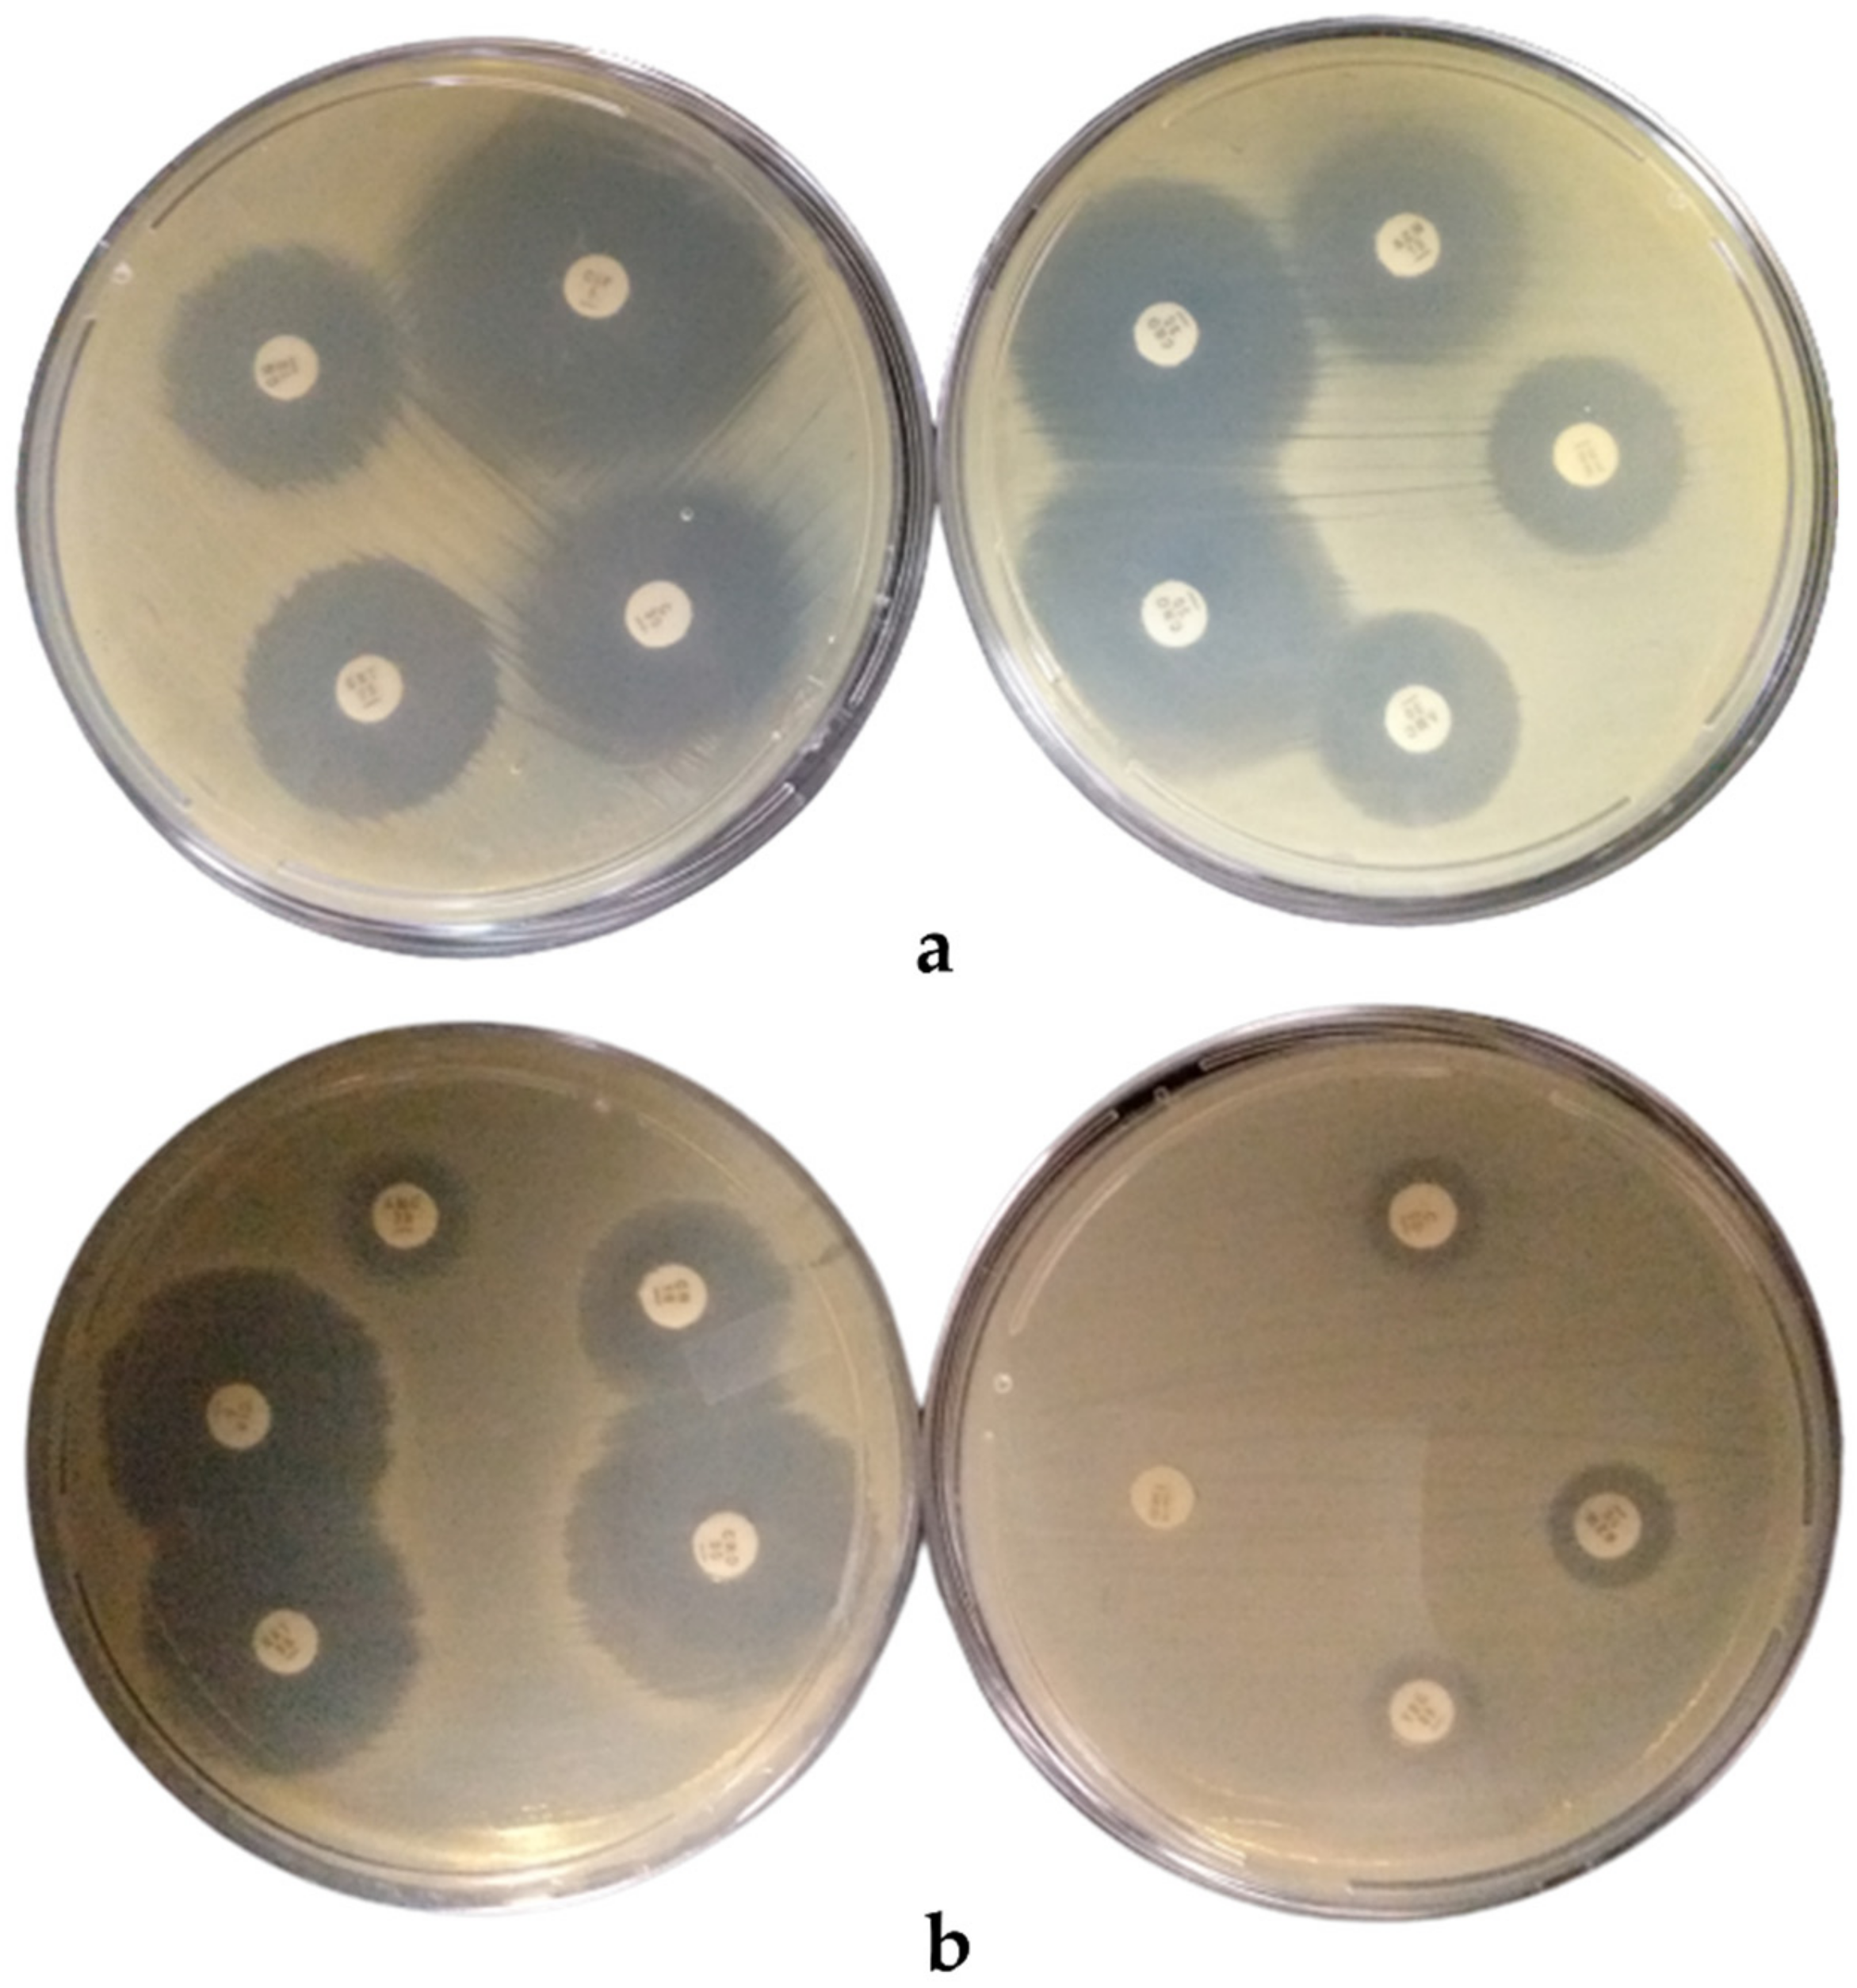
Foods 10 01011 g001

Not All Street Food Is Bad: Low Prevalence of Antibiotic-Resistant Salmonella enterica in Ready-to-Eat (RTE) Meats in Ghana Is Associated with Good Vendors’ Knowledge of Meat Safety
Abstract
1. Introduction
2. Materials and Methods
2.1. Study Area
2.2. Study Design, Population, and Questionnaire Administration
2.3. Microbial Load
2.4. Isolation of Salmonella Enterica
2.5. Antibiotic Resistance Test
2.6. Statistical Analysis
3. Results
3.1. Demographic Characteristics of Ready-to-Eat (RTE) Meat Vendors and Consumers
3.2. Microbial Load and Prevalence of Salmonella Enterica in RTE Meats
3.3. Prevalence and Antibiotic Resistance of Salmonella enterica Isolated from RTE Meats
4. Discussion
5. Conclusions
Supplementary Materials
Author Contributions
Funding
Institutional Review Board Statement
Informed Consent Statement
Data Availability Statement
Acknowledgments
Conflicts of Interest
References
- Ahmad, R.S.; Imran, A.; Hussain, M.B. Nutritional Composition of Meat. 2018. Available online: https://www.intechopen.com/books/meat-science-and-nutrition/nutritional-composition-of-meat (accessed on 9 September 2020).
- Bintsis, T. Foodborne pathogens. AIMS Microbiol. 2017, 3, 529–563. [Google Scholar] [CrossRef] [PubMed]
- Ashwathi, P. Growth of Microorganisms in Meat. 2020. Available online: https://www.biologydiscussion.com/food-microbiology/growth-of-microorganisms-in-meat-microbiology/66131 (accessed on 9 September 2020).
- Anachinaba, I.A.; Adzitey, F.; Teye, G.A. Assessment of the microbial quality of locally produced meat (beef and pork) in Bolgatanga Municipal of Ghana. Internet J. Food Safe 2015, 17, 1–5. [Google Scholar]
- European Food Safety Authority and European Centre for Disease Prevention and Control. The European Union summary report on trends and sources of zoonoses, zoonotic agents and foodborne outbreaks in 2017. EFSA J. 2018, 16, 1–262. [Google Scholar]
- Tay, M.Y.F.; Adzitey, F.; Sultan, S.A.; Tati, J.M.; Seow, K.L.G.; Schlundt, J. Whole-genome sequencing of nontyphoidal Salmonella enterica isolates obtained from various meat types in Ghana. Microbiol. Res. Announc. 2019, 8, e00033-19. [Google Scholar] [CrossRef]
- Adzitey, F. Incidence and antimicrobial susceptibility of Escherichia coli isolated from beef (meat muscle, liver and kidney) samples in Wa Abattoir, Ghana. Cogent Food Agric. 2020, 6, 2–10. [Google Scholar] [CrossRef]
- Adzitey, F.; Ekli, R.; Aduah, M. Incidence and antibiotic susceptibility of Staphylococcus aureus isolated from ready-to-eat meats in the environs of Bolgatanga Municipality of Ghana. Cogent Environ. Sci. 2020, 6, 1791463. [Google Scholar] [CrossRef]
- Omer, M.K.; Álvarez-Ordoñez, A.; Prieto, M.; Skjerve, E.; Asehun, T.; Alvseike, O.A. A Systematic review of bacterial foodborne outbreaks related to red meat and meat Products. Foodborne Pathog. Dis. 2018, 15, 598–611. [Google Scholar] [CrossRef]
- Centers for Disease Prevention and Control. Burden of Foodborne Illness: Findings. 2020. Available online: https://www.cdc.gov/foodborneburden/2011-foodborne-estimates.html (accessed on 9 September 2020).
- World Health Organization. Food Safety. 2020. Available online: https://www.who.int/news-room/fact-sheets/detail/food-safety (accessed on 9 September 2020).
- US Food and Drug Administration. Foodborne Pathogens. 2020. Available online: https://www.fda.gov/food/outbreaks-foodborne-illness/foodborne-pathogens (accessed on 9 September 2020).
- Laufer, A.S.; Grass, J.; Holt, K.; Whichard, J.M.; Griffin, P.M.; Gould, L.H. Outbreaks of Salmonella infections attributed to beef—United States, 1973–2011. Epidemiol. Infect. 2015, 143, 2003–2013. [Google Scholar] [CrossRef]
- Marshall, B.M.; Levy, S.B. Food animals and antimicrobials: Impacts on human health. Clin. Microbiol. Rev. 2011, 24, 718–733. [Google Scholar] [CrossRef]
- Akbar, A.; Anal, A.K. Isolation of Salmonella from ready-to-eat poultry meat and evaluation of its survival at low temperature, microwaving and simulated gastric fluids. J. Food Sci. Technol. 2015, 52, 3051–3057. [Google Scholar] [CrossRef]
- Angkititrakul, S.; Chomvarin, C.; Chaita, T.; Kanistanon, K.; Waethewutajarn, S. Epidemiology of antimicrobial resistance in Salmonella isolated from pork, chicken meat and humans in Thailand. Southeast Asian J. Trop. Med. Public Health 2005, 36, 510–1515. [Google Scholar]
- Rane, S. Street vended food in developing world: Hazard analyses. Indian J. Microbiol. 2011, 51, 100–106. [Google Scholar] [CrossRef]
- Ghana Statistical Service (GSS). 2010 Population and Housing Census. 2012. Available online: www.statsghana.gov.gh/.../2010phc/Census2010_Summary_report_of_final_ results.p (accessed on 9 September 2020).
- Anonymous. Sample size Calculator. 2020. Available online: https://www.calculator.net/sample-size-calculator.html?type=1&cl=95&ci=5&pp=50&ps =66685 &x=39&y=22 (accessed on 23 August 2019).
- Maturin, L.; Peeler, J.T. Bacteriological Analytical Manual, Chapter 3, Aerobic Plate Count. 2001. Available online: https://www.fda.gov/food/laboratory-methods-food/bam-aerobic-plate-count (accessed on 23 August 2018).
- Andrews, W.H.; Wang, H.; Jacobson, A.; Hammack, T. Bacteriological Analytical Manual (BAM), Chapter 5: Salmonella enterica. 2018. Available online: https://www.fda.gov/food/laboratory-methods-food/bacteriological-analytical-manual-bam-chapter-5-Salmonella enterica (accessed on 23 August 2018).
- Bauer, A.W.; Kirby, W.M.M.; Sherris, J.C.; Turk, M. Antibiotic susceptibility testing by a standardized single disc method. Am. J. Clin. Pathol. 1966, 45, 493–496. [Google Scholar] [CrossRef]
- Clinical and Laboratory Standard Institute. Performance Standards for Antimicrobial Disk and Dilution Susceptibility Tests for Bacteria Isolated from Animals, Approved Standard, 3rd ed.; Clinical and Laboratory Standards Institute: Wayne, PA, USA, 2017. [Google Scholar]
- Adesokan, H.K.; Raji, A.O.Q. Safe meat-handling knowledge, attitudes and practices of private and government meat processing plants’ workers: Implications for future policy. J. Prev. Med. Hyg. 2014, 55, 10–16. [Google Scholar]
- Tegegne, H.A.; Phyo, H.W.W. Food safety knowledge, attitude and practices of meat handler in abattoir and retail meat shops of Jigjiga Town, Ethiopia. J. Prev. Med. Hyg. 2017, 58, E320–E327. [Google Scholar]
- Adzitey, F.; Sulleyman, K.W.; Mensah, S.S. Knowledge and practices of meat safety by meat sellers in the Kumasi Metropolis of Ghana. Res. Rev. J. Food Sci. Tech. 2018, 7, 31–41. [Google Scholar]
- Sulleyman, K.W.; Adzitey, F.; Boateng, E.F. Knowledge and practices of meat safety by meat sellers in the Accra Metropolis of Ghana. Inter. J. Vet. Sci. 2018, 7, 167–171. [Google Scholar]
- Adzitey, F.; Sulleyman, K.W.; Kum, P.K. Knowledge and practices of meat safety by meat sellers in the Tamale Metropolis of Ghana. Food Prot. Trends 2020, 40, 40–47. [Google Scholar]
- Ghana Standard Authority. Microbiological Criteria for Foods. Available online: https://www.gsa.gov.gh/standards/ (accessed on 9 September 2020).
- Centre for Food Safety. Microbiological Guidelines for Food. Available online: www.cfs.gov.hk (accessed on 9 September 2020).
- Ampaw, A.B. Prevalence of Listeria Monocytogenes in ‘Khebab’, a Street-Vended Spicy Grilled Meat. Master’s Thesis, Kwame Nkrumah University of Science and Technology, Kumasi, Ghana, 2018. [Google Scholar]
- Agbodaze, D.; Nmai, P.N.; Robertson, F.; Yeboah-Manu, D.; Owusu-Darko, K.; Addo, K. Microbiological quality of khebab consumed in the Accra metropolis. Ghana Med. J. 2015, 39, 46–49. [Google Scholar] [CrossRef]
- Khaitsa, M.L.; Kegode, R.B.; Doetkott, D.K. Occurrence of antimicrobial-resistant Salmonella species in raw and ready to eat turkey meat products from retail outlets in the Midwestern United States. Foodborne Pathog. Dis. 2007, 4, 517–525. [Google Scholar] [CrossRef]
- Cabedo, L.; Picart, B.L.; Teixidó, C.A. Prevalence of Listeria monocytogenes and Salmonella in ready-to-eat food in Catalonia, Spain. J. Food Prot. 2008, 71, 855–859. [Google Scholar] [CrossRef] [PubMed]
- Yang, S.; Pei, X.; Wang, G.; Yan, L.; Hu, J.; Li, Y.; Li, N.; Yang, D. Prevalence of foodborne pathogens in ready-to-eat meat products in seven different Chinese Regions. Food Control 2016, 65, 92–98. [Google Scholar] [CrossRef]
- Terentjeva, M.; Avsejenko, J.; Streikiša, M.; Utināne, A.; Kovaļenko, K.; Bērziņš, A. Prevalence and antimicrobial resistance of Salmonella in meat and meat products in Latvia. Ann. Agric. Environ. Med. 2017, 24, 317–321. [Google Scholar] [CrossRef] [PubMed]
- Thai, T.H.; Hirai, T.; Lan, N.T.; Yamaguchi, R. Antibiotic resistance profiles of Salmonella serovars isolated from retail pork and chicken meat in North Vietnam. Int. J. Food Microbiol. 2012, 156, 147–151. [Google Scholar] [CrossRef] [PubMed]
- Mokgophi, T.M.; Gcebe, N.; Fasina, F.; Adesiyun, A.A. Antimicrobial resistance profiles of Salmonella isolates on chickens processed and retailed at outlets of the informal market in Gauteng Province, South Africa. Pathogens 2021, 10, 273. [Google Scholar] [CrossRef] [PubMed]
- Rašeta, M.; Mrdović, B.; Janković, V.; Bečkei, Z.; Lakićević, B.; Vidanović, D.; Polaček, V. Prevalence and antibiotic resistance of Salmonella spp. in meat products, meat preparations and minced meat. IOP Conf. Ser. Earth Environ. Sci. 2017, 85, 12028. [Google Scholar] [CrossRef]
- Abass, A.; Adzitey, F.; Huda, N. Escherichia coli of ready-to-eat (RTE) meats origin showed resistance to antibiotics used by farmers. Antibiotics 2020, 9, 869. [Google Scholar] [CrossRef]
- Sofy, A.R.; Sharaf, A.E.M.A.; Al Karim, A.G.A.; Hmed, A.A.; Moharam, K.M. Prevalence of the harmful Gram-negative bacteria in ready-to-eat foods in Egypt. Food Pub. Health 2017, 7, 59–68. [Google Scholar]
- Mohammed, A.M. Contamination of Ready to Eat Vended Food of Meat Origin with Aerobic Bacteria in Khartoum State. Master’s Thesis, University of Khartoum, Khartoum, Sudan, 2004. [Google Scholar]
- Harakeh, S.; Yassine, H.; Gharios, M.; Barbour, E.; Hajjar, S.; El-Fadel, M.; Toufeili, I.; Tannous, R. Isolation, molecular characterization and antibiotic resistance patterns of Salmonella and Escherichia coli isolates from meat-based fast food in Lebanon. Sci. Total Environ. 2005, 341, 33–44. [Google Scholar] [CrossRef]
- Lapierre, L.; Cornejo, J.; Zavala, S.; Galarce, N.; Sánchez, F.; Benavides, M.B.; Guzmán, M.; Sáenz, L. Phenotypic and genotypic characterization of virulence factors and susceptibility to antibiotics in Salmonella Infantis strains isolated from chicken meat: First findings in Chile. Animals 2020, 10, 1049. [Google Scholar] [CrossRef]
| RTE Meat Vendors | RTE Meat Consumers | ||
|---|---|---|---|
| Variables | Freq./Per. (%) | Variables | Freq./Per. (%) |
| Gender | Gender | ||
| Male | 293 (97.7) | Male | 274 (71.7) |
| Female | 7 (2.3) | Female | 108 (28.3) |
| Age | Age | ||
| Below 21 years | 2 (0.7) | Below 21 years | 35 (9.2) |
| 21–40 years | 231 (77.3) | 21–40 years | 250 (65.4) |
| 41–60 years | 66 (22.1) | 41–60 years | 87 (22.8) |
| Above 60 years | 0 (0.0) | Above 60 years | 10 (2.6) |
| Educational background | Educational background | ||
| None | 74 (24.7) | None | 48 (12.6) |
| Basic | 221 (73.7) | Basic | 207 (54.2) |
| Secondary | 5 (1.7) | Secondary | 86 (22.5) |
| Tertiary | 0 (0.0) | Tertiary | 32 (8.4) |
| Others | 0 (0.0) | Others | 9 (2.4) |
| Nationality | How often do you consume RTE meat | ||
| Ghanaian | 265 (89.5) | Daily | 20 (5.2) |
| Burkinabe | 7 (2.4) | Once a month | 114 (29.8) |
| Malian | 16 (5.4) | 2–3 times a week | 29 (7.6) |
| Nigerien | 8 (2.7) | Once a week | 219 (57.3) |
| Years in business | What prompts you consume it | ||
| Less than a year | 0 (0.0) | My ‘’mouth sweet’’ me | 22 (5.8) |
| 1–5 years | 131 (43.7) | When I go out with friends | 332 (86.9) |
| 6–10 years | 130 (43.3) | For home consumption | 27 (7.1) |
| Above 10 years | 39 (13.0) | Others | 1 (0.3) |
| Type of grilled RTE meat sold | Type of grilled RTE meat preferred | ||
| Pork | 50 (16.7) | Pork | 32 (8.4) |
| Mutton | 49 (16.3) | Mutton | 22 (5.8) |
| Guinea fowl | 51 (17.0) | Guinea fowl | 266 (69.6) |
| Chevon | 49 (16.3) | Chevon | 43 (11.3) |
| Beef | 51 (17.0) | Beef | 19 (5.0) |
| Chicken | 50 (16.7) | Reason for product preference | |
| Reason for product preference | Cheaper | 6 (1.6) | |
| Consumer preference | 285 (95.0) | It is safe | 2 (0.5) |
| Religion | 9 (3.0) | Readily available | 3 (0.8) |
| Cheaper | 6 (2.0) | Has good taste | 341 (89.3) |
| Occupational status | It is healthy | 30 (7.9) | |
| Full-time | 281 (93.7) | ||
| Part-time | 19 (6.3) | ||
| Alternative occupation if part-time | |||
| Farming | 22 (7.3) | ||
| Number of shops | |||
| One | 290 (96.7) | ||
| Two | 10 (3.3) | ||
| RTE Meat Vendors | RTE Meat Consumers | ||||
|---|---|---|---|---|---|
| Response | Response | ||||
| Variables | Yes: n (%) | No: n (%) | Variables | Yes: n (%) | No: n (%) |
| Have you ever heard of meat safety | 295 (98.3) | 5 (1.7) | Have you ever heard of meat safety | 358 (91.8) | 21 (5.5) |
| Do you know that meat can be contaminated by poor handling | 300 (100) | 0 (0.0) | Do you know that meat can be contaminated by poor handling | 327 (88.9) | 26 (7.1) |
| Knowledge on meat-borne diseases | 289 (96.3) | 6 (2.0) | Do you know that eating, drinking, and smoking by vendors while RTE meat increases the risk of contamination | 70 (19.0) | 282 (76.6) |
| Received training on meat safety | 254 (85.5) | 43 (14.5) | Do you know that regular washing of hands by vendors reduces the risk of contamination | 359 (94.0) | 23 (6.0) |
| Aware that eating, drinking, and smoking while selling meat increases the risk of meat contamination | 297 (99.0) | 3 (1.0) | |||
| Aware that regular washing of hands reduces the risk of meat contamination | 300 (100) | 0 (0.0) | |||
| Aware that using sterilized gloves reduces the risk of meat contamination | 298 (99.3) | 2 (0.7) | |||
| Know that there is the need to take leave from work when infected with any disease | 296 (98.7) | 4 (1.3) | |||
| Know that it is necessary to refrigerate leftover meat | 284 (94.7) | 16 (5.3) | |||
| Ready-to-Eat (RTE) Meat Vendors | Ready-to-Eat (RTE) Meat Consumers | ||
|---|---|---|---|
| Variables | Freq./Per. (%) | Variables | Freq./Per. (%) |
| Source of meat for grilling | How should leftover grilled RTE meat be stored? | ||
| Backyard slaughter | 111 (37.0) | Refrigeration | 256 (67.0) |
| Abattoir | 182 (60.7) | Salting | 8 (2.1) |
| Imported carcass | 7 (2.3) | Smoking | 105 (27.5) |
| Reasons for choice of source | Frying | 13 (3.4) | |
| Safe and quality | 182 (60.7) | ||
| Readily available | 110 (36.7) | Where do you buy your grilled RTE meat? | |
| Cheap | 8 (2.7) | Market | 63 (16.5) |
| What do you sell meat on/in? | Roadside | 208 (54.5) | |
| An open table | 7 (2.3) | Restaurant | 35 (9.2) |
| Table with a net covering the meat | 144 (48) | Drinking bar | 76 (19.9) |
| Glass sieve | 121 (40.3) | ||
| Others | 28 (9.3) | How is the RTE meat that you buy normally displayed? | |
| Frequency of washing cutting tables | On open table | 58 (15.2) | |
| At the beginning of work | 20 (6.7) | Table with wire mesh covering | 170 (44.5) |
| At the end of work | 5 (1.7) | Glass sieve | 147 (38.5) |
| At the beginning and at the end of work | 275 (91.7) | Others | 7 (1.8) |
| Do you disinfect your shop? | |||
| Yes | 298 (99.3) | Do you wash your hands before touching or eating RTE meat? | |
| No | 2 (0.7) | Yes | 93 (24.8) |
| How often do you disinfect your shop? | No | 261 (69.6) | |
| Once a week | 128 (42.7) | ||
| Twice a week | 171 (57.0) | What do you use to wash if yes? | |
| Others | 1 (0.3) | Only water | 220 (73.3) |
| Type of disinfectant used | Soap and water | 80 (26.7) | |
| Isopropyl alcohol | 284 (94.7) | ||
| Iodine | 12 (4.0) | Where do you eat your RTE meat? | |
| Hydrogen peroxide | 4 (1.3) | On the street | 47 (12.3) |
| Frequency of washing hands before touching meat | At home | 85 (22.3) | |
| Always | 299 (99.7) | In a drinking bar | 222 (58.1) |
| Sometimes | 1 (0.3) | On the vendors’ table | 28 (7.3) |
| Yes | 300 (100.0) | ||
| Only water | 1 (0.3) | ||
| Detergent and water | 298 (99.3) | ||
| Others | 1 (0.3) | ||
| Water | 228 (76.0) | ||
| Warm water | 72 (24.0) | ||
| Sterilization of cutting tools and other equipment | |||
| Yes | 283 (94.3) | ||
| No | 17 (5.7) | ||
| Daily | 161 (53.8) | ||
| Twice a week | 10 (3.3) | ||
| Weekly | 126 (42.1) | ||
| Others | 2 (0.7) | ||
| Yes | 294 (98.0) | ||
| No | 5 (1.7) | ||
| Everyday | 272 (91.3) | ||
| Twice a week | 18 (6.0) | ||
| Once a week | 8 (2.7) | ||
| Always | 9 (3.0) | ||
| Sometimes | 204 (68.0) | ||
| Rarely | 65 (21.7) | ||
| Never | 22 (7.3) | ||
| Yes | 5 (1.7) | ||
| No | 295 (98.3) | ||
| Very dirty | 1 (0.3) | ||
| Dirty | 4 (1.3) | ||
| Clean | 99 (33.0) | ||
| Very clean | 196 (65.3) | ||
| Refrigeration | 284 (94.7) | ||
| Smoking | 16 (5.3) | ||
| Frying/Salting | 0 (0.0) | ||
| RTE Meat Type | Total Sample Tested | No. (%) Positive | * Bacteria Load (log cfu/cm2 |
|---|---|---|---|
| Mutton | 50 | 1 (2.00) | 4.17 bc |
| Chevon | 50 | 1 (2.00) | 4.85 c |
| Pork | 50 | 1 (2.00) | 4.02 bc |
| Guinea Fowl | 50 | 2 (4.00) | 4.06 bc |
| Chicken | 50 | 1(2.00) | 2.53 a |
| Beef | 50 | 0 (0.00) | 3.37 ab |
| Total/average | 300 | 6 (2.00) | 3.83 |
| Antimicrobial | Resistant (%) | Susceptible (%) |
|---|---|---|
| Amoxycillin/Clavulanic acid 30 ug (AMC) | 66.67 | 33.33 |
| Azithromycin 15 ug (AZM) | 83.33 | 16.67 |
| Ceftriaxone 30 ug (CRO) | 0.00 | 50.00 |
| Chloramphenicol 30 ug (CHL) | 0.00 | 83.33 |
| Ciprofloxacin 5 ug (CIP) | 0.00 | 83.33 |
| Gentamycin 10 ug (GEN) | 16.67 | 33.33 |
| Teicoplanin 30 ug (TEC) | 100.00 | 0.00 |
| Tetracycline 30 ug (TET) | 50.00 | 0.00 |
| Sulfamethoxazole/Trimethoprim (SXT) | 0.00 | 100.00 |
| Overall | 35.19 | 44.44 |
| Codes | Meat Type | Number of Antibiotics | Antibiotic-Resistant Profile | MAR Index |
|---|---|---|---|---|
| S7 | Mutton | 5 | AMC-AZM-TEC-TET-CHL | 0.56 |
| P3 | Pork | 2 | AZM-TEC | 0.22 |
| Go44 | Chevon | 4 | AZM-TEC-GEN-TET | 0.44 |
| G44 | Guinea fowl | 2 | AMC-TEC | 0.22 |
| G49 | Guinea fowl | 3 | AMC-AZM-TEC | 0.33 |
| C16 | Chicken | 4 | AMC-AZM-TEC-TET | 0.44 |
Publisher’s Note: MDPI stays neutral with regard to jurisdictional claims in published maps and institutional affiliations. |
© 2021 by the authors. Licensee MDPI, Basel, Switzerland. This article is an open access article distributed under the terms and conditions of the Creative Commons Attribution (CC BY) license (https://creativecommons.org/licenses/by/4.0/).
Share and Cite
Aduah, M.; Adzitey, F.; Amoako, D.G.; Abia, A.L.K.; Ekli, R.; Teye, G.A.; Shariff, A.H.M.; Huda, N. Not All Street Food Is Bad: Low Prevalence of Antibiotic-Resistant Salmonella enterica in Ready-to-Eat (RTE) Meats in Ghana Is Associated with Good Vendors’ Knowledge of Meat Safety. Foods 2021, 10, 1011. https://doi.org/10.3390/foods10051011
Aduah M, Adzitey F, Amoako DG, Abia ALK, Ekli R, Teye GA, Shariff AHM, Huda N. Not All Street Food Is Bad: Low Prevalence of Antibiotic-Resistant Salmonella enterica in Ready-to-Eat (RTE) Meats in Ghana Is Associated with Good Vendors’ Knowledge of Meat Safety. Foods. 2021; 10(5):1011. https://doi.org/10.3390/foods10051011
Chicago/Turabian StyleAduah, Martin, Frederick Adzitey, Daniel Gyamfi Amoako, Akebe Luther King Abia, Rejoice Ekli, Gabriel Ayum Teye, Amir H. M. Shariff, and Nurul Huda. 2021. "Not All Street Food Is Bad: Low Prevalence of Antibiotic-Resistant Salmonella enterica in Ready-to-Eat (RTE) Meats in Ghana Is Associated with Good Vendors’ Knowledge of Meat Safety" Foods 10, no. 5: 1011. https://doi.org/10.3390/foods10051011
APA StyleAduah, M., Adzitey, F., Amoako, D. G., Abia, A. L. K., Ekli, R., Teye, G. A., Shariff, A. H. M., & Huda, N. (2021). Not All Street Food Is Bad: Low Prevalence of Antibiotic-Resistant Salmonella enterica in Ready-to-Eat (RTE) Meats in Ghana Is Associated with Good Vendors’ Knowledge of Meat Safety. Foods, 10(5), 1011. https://doi.org/10.3390/foods10051011

